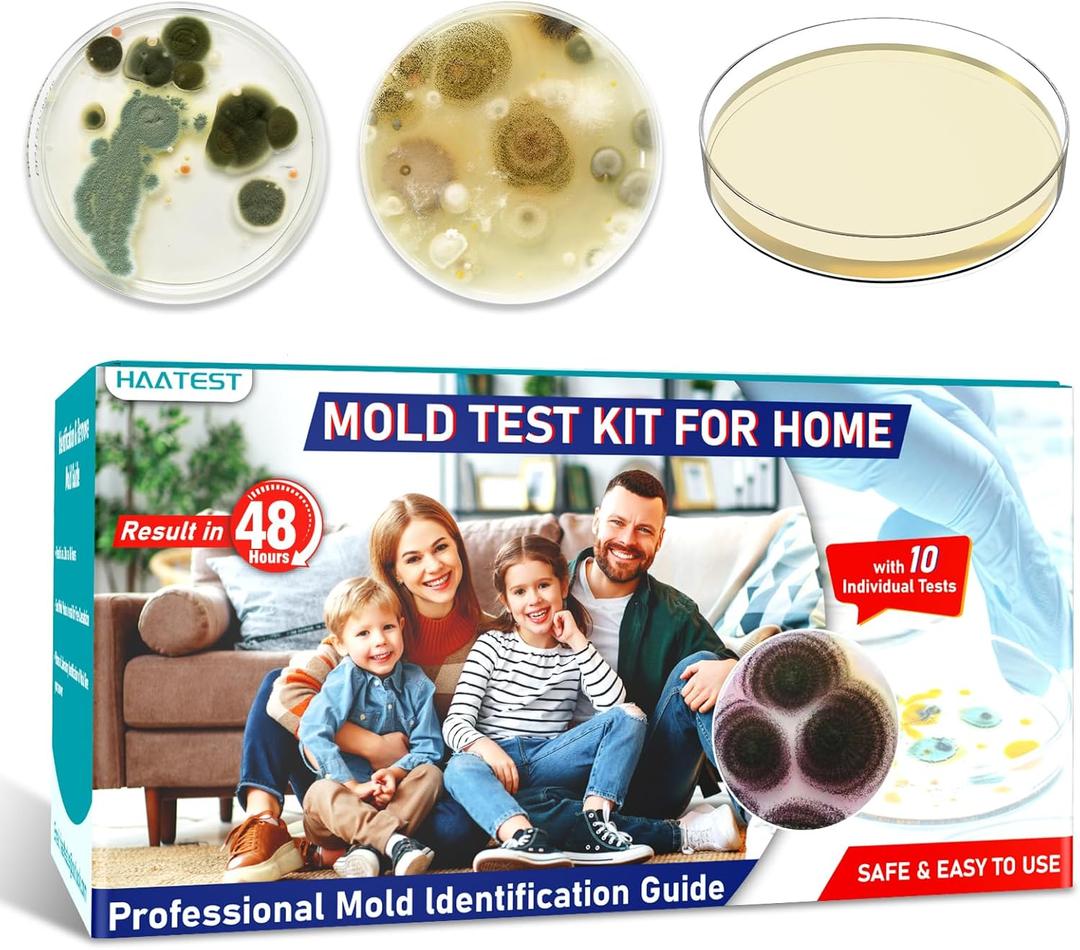
Mold Test Kit for Home: 10 Simple Mold Detector with Detailed Identification Guide for Surfaces Indoor Air Quality HVAC Testing Results in 48 Hours at Home Black Mold Detection Kit

Mold Test Kit for Home: 10 Simple Mold Detector with Detailed Identification Guide for Surfaces Indoor Air Quality HVAC Testing Results in 48 Hours at Home Black Mold Detection Kit
Condition: New
Pickup Details
| Thursday, Nov 13 | 08:00AM - 02:00PM |
| Friday, Nov 14 | 09:00AM - 02:00PM (Appointment only) |
| Saturday, Nov 15 | 08:30AM - 02:00PM |
| Monday, Nov 17 | 11:00AM - 06:30PM (Appointment only) |
Product Details
| SKU | OLARR4824174 |
| ASIN | B0FCG889W2 |